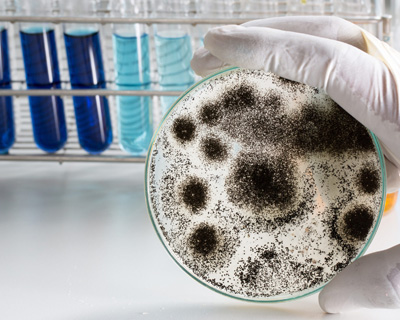
Healthcare facilities

Hotels, resorts, and restaurants
Clinics, hospitals, and care facilities

Schools, universities, and daycare

Factories and production facilities
Our certified commercial team is ready to respond 24/7 to protect your property and operations
© 2025-2026. 5 Star Services LLC. Rights Reserved.
Website Development |
Hosting | SEO | Digital Marketing
